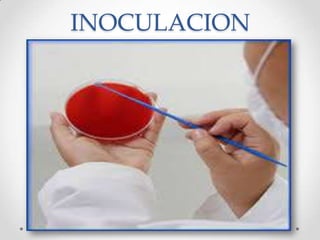
INOCULACION
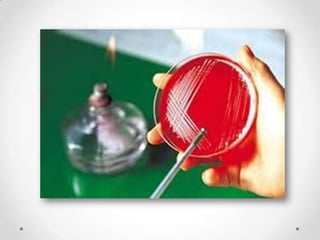
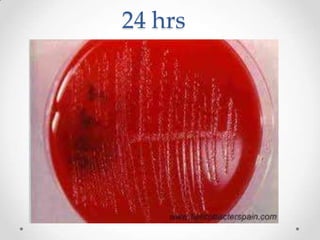
24 hrs
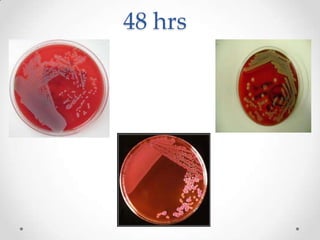
48 hrs
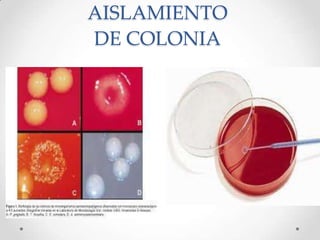
AISLAMIENTO
DE COLONIA
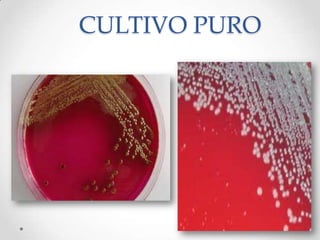
CULTIVO PURO
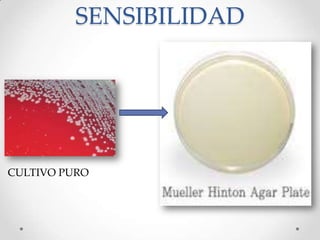
SENSIBILIDAD
CULTIVO PURO
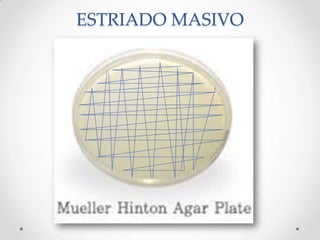
ESTRIADO MASIVO
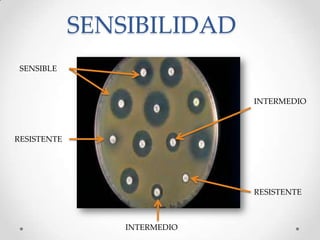
SENSIBILIDAD
SENSIBLE
INTERMEDIO
RESISTENTE
RESISTENTE
INTERMEDIO

Incrustar presentación
Descargado 476 veces










































El documento describe las técnicas de aislamiento bacteriano utilizadas en un laboratorio de microbiología. Estas incluyen cultivos mixtos y puros, así como técnicas como la siembra por estriado, vaciado en placa, dilución y agitación para aislar un solo microorganismo del medio y permitir su identificación. Se explican también los medios de cultivo, obtención de muestras, incubación, aislamiento de colonias, tinción de Gram, morfología bacteriana y pruebas de sensibilidad para determinar